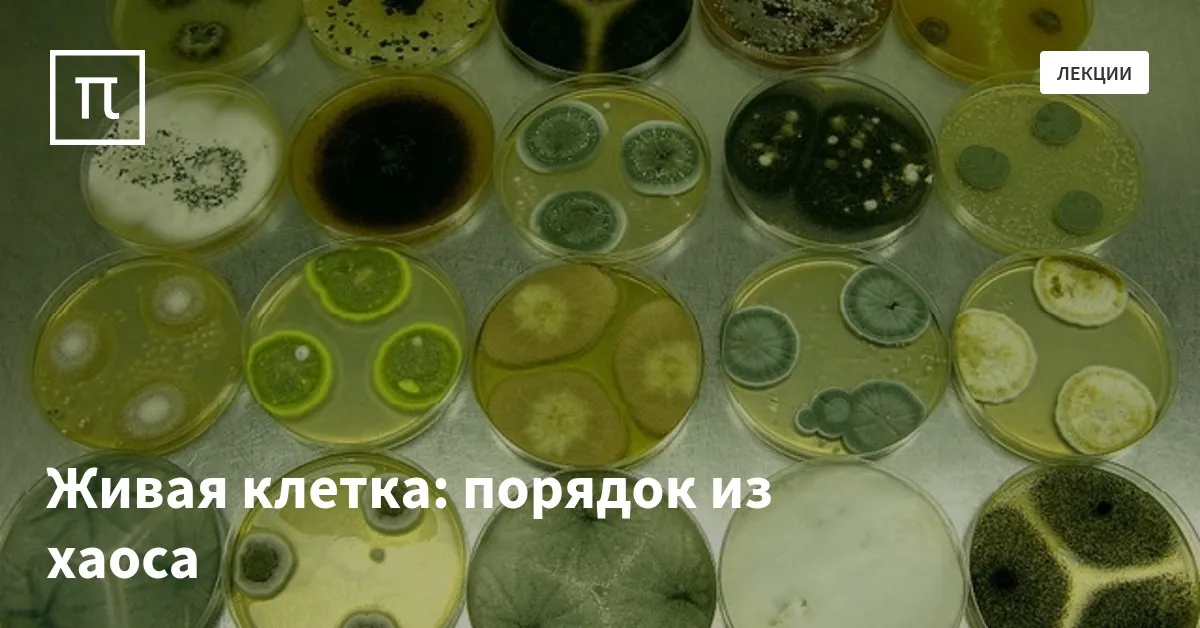

Создали живую клетку
Создали живую клетку 109 фотографий
Кремль 2222 сталкер аудиокнига
Ломбард валантис новокузнецкая
Какие классы учатся летом
Магазин слово в спб
Датчик абс bosch
Lauma medical
Усилитель acv отзывы
Ул станционная благовещенск
12 января 1848
Пройдемся немного
Urmary cap
Ботанический сад задачи
Сообщение электрического тока
Amp tag
В треугольниках abd acd ab ac
Сочинение 13.3 вывод
141 еа маршрут следования
Последние часы заворотнюк видео
Gta ico
Свидетельства паранормального 2017